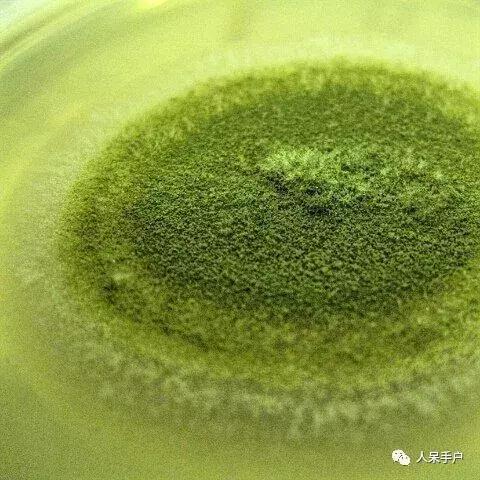
黄曲霉毒素真的有这么可怕吗,黄曲霉素的特点

人呆手户
“人呆手户”即保护:保护植物,保护绿色,保护自然,保护生命?
MAY BE! 我们更愿意保护的是你喜欢阅读、热爱自然的心意。
——《植物保护学报》官方微平台
我们浏览新闻时,
经常会看到关于黄曲霉毒素的报道,
比如,某某产品被检出黄曲霉毒素超标,
某某人因黄曲霉毒素中毒等等。

人们对于黄曲霉毒素似乎
有着非同寻常的关注度,
只要提起,
总能引起激烈地讨论。
网络上甚至出现一些不法人士,
借助人们“谈霉色变”的恐惧心理,
大肆散播谣言。

看到这里,
大家肯定想要知道,
这个自带流量的主角
黄曲霉毒素到底是什么?
它来自哪里?
它的危害究竟有多大?
我们该如何预防它的危害呢?

想得脑袋疼
+ 追根溯源之黄曲霉 +

黄曲霉菌Aspergillus flavus是广泛分布于自然界的腐生真菌,属于发菌科曲霉属Aspergillus,是人和动、植物的共同病原菌。

黄曲霉毒素(aflatoxin,AFT)属于真菌毒素,是高毒性次生代谢产物。它虽然叫作黄曲霉毒素但是却并不是只由黄曲霉产生,寄生曲霉 (Aspergillus parasiticus)也可以生成该毒素。其他真菌如毛霉、青霉、镰孢曲霉等也是产生黄曲霉毒素的菌种。

黄曲霉毒素并不是一种毒素,它实际上是指化学结构相似的一组衍生物。目前,已经分离鉴定出的黄曲霉毒素已有20余种,最为常见的为B族黄曲霉毒素(B1、B2)、G族黄曲霉毒素(G1、G2)、M族黄曲霉毒素(M1、M2)以及毒醇等。

不同化学结构的黄曲霉毒素
+ 黄曲霉毒素哪里找?+

黄曲霉毒素可侵染多种食品,如我们经常吃的干果,花生、瓜子、核桃、开心果等。

谷物如玉米、大米、大麦、小麦、豆类等当中也会发现黄曲霉毒素。而由花生、玉米等为材料制作的粮油也很可能中招。

而当奶牛食用了含有黄曲霉毒素的饲料后,其产出的牛奶中也很有可能带有毒素。当然,一旦人类饮用了这些牛奶,黄曲霉毒素也会随之进入人体内。

这些看不见的黄曲霉毒素可以发生在从田间采收、处理、输送到贮藏的食品链的每一个环节。任何一个环节的疏忽都可能带来意想不到的后果。
+ 小小黄曲霉毒素危害大+
黄曲霉毒素之所以能在人们当中引起这么大的反响,还得归功于它对于人体伤害大。

黄曲霉毒素“出生”就不平凡。1960年在英国的南部地区,短短数月内有十万只火鸡突然死亡,由于病因不明,当时称为“火鸡 X 病”,后来证实是因为火鸡饲料中含有霉变的花生粉。

发霉的花生
1961年,人们发现使花生霉变的是黄曲霉菌,并于翌年分离并鉴定出其中的致癌物质,把它命名为黄曲霉毒素。
培养基上的黄曲霉
从此,人们对于黄曲霉毒素开展了各种研究。到1993年,黄曲霉毒素被世界卫生组织(WHO)癌症研究机构划定为Ⅰ类天然存在的致癌物,为毒性极强的剧毒物质。
那到底有多毒呢?我们做个比较就知道了,黄曲霉毒素的毒性是敌敌畏的100倍、*霜砒**的68倍、氰化钾的10倍,甚至比眼镜蛇、金环蛇的毒汁还要毒。

而它的致癌能力是二甲基亚硝胺的70倍、苯荓芘400倍。在一众黄曲霉毒素中,AFB1的毒性最强,是目前已知的毒性最强的致癌性真菌毒素。

那这么厉害的黄曲霉毒素我们该如何避免中招呢?
1. 买东西勿贪多,存储不当易发霉。
许多爱囤囤囤的小伙伴可千万要注意了,防止霉变是预防食品被黄曲霉毒素污染的有效措施。一次买太多,存储时又不注意在通风干燥处保存,那食品发霉就是早晚的问题。

2.小作坊榨油有风险,买油认准正规品牌
一般小作坊的榨油工艺简单,对于有害物质不能去除,一些外表正常但内部已霉变的花生很可能掺杂其中。

3. 发苦食物勿再吃
当你在吃吃吃时,如果一不小心吃到发苦的花生、瓜子,不要偷懒,要立即吐掉并用水漱口。

4.日常小妙招,可以减少毒素发生
油热后,先加盐。当花生油中有少量黄曲霉毒素污染时可用此法。即炒菜时先将油倒入锅内加热,当有微烟冒出时,加少许食盐爆锅10~20s,再倒入菜同炒。

加水搓洗或用高压锅煮饭,适用于家庭中大米去毒。另外,平常多吃如胡萝卜、芹菜和香菜等蔬菜可能会降低黄曲霉毒素的致癌作用。

当然,最好最简单粗暴的方法就是看到霉变的直接扔掉。

不要犹豫地丢掉、丢掉
怎么样,
有没有学到这些办法?
如果你还有更好的小妙招,
欢迎留言分享~

图片来源:Pinterest Google 图片来源见
水印
劳文艳等 《黄曲霉毒素对食品的污染及危
害》
如有侵权 联系删除
本期小编:桃花岛主
原创作品 欢迎个人转发到朋友圈
公众号转载
1.请标注作者、微信名、微信号、二维码
2.请尊重原创,保留“人呆手户”名片
3.授权联系:zbxb7@cau.edu.cn